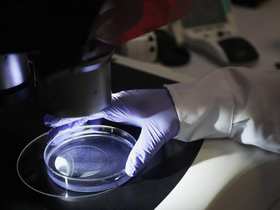

Всі новини з тегом: хищение
03 листопада 2025 г.
23:54
23:36
23:24
23:19
Загрузка...
Білий дім звинуватив демократів у шатдауні, представивши їх у вигляді привидів на відео до Геловіну
 3
3
Співака-путініста Лепса терміново госпіталізували з важким отруєнням після концерту у Владивостоці
 3
3
Наші опитування
Чи вірите ви, що Дональд Трамп зможе зупинити війну між Росією та Україною?
Показати результати опитування
Показати всі опитування на сайті
Показати результати опитування
Показати всі опитування на сайті